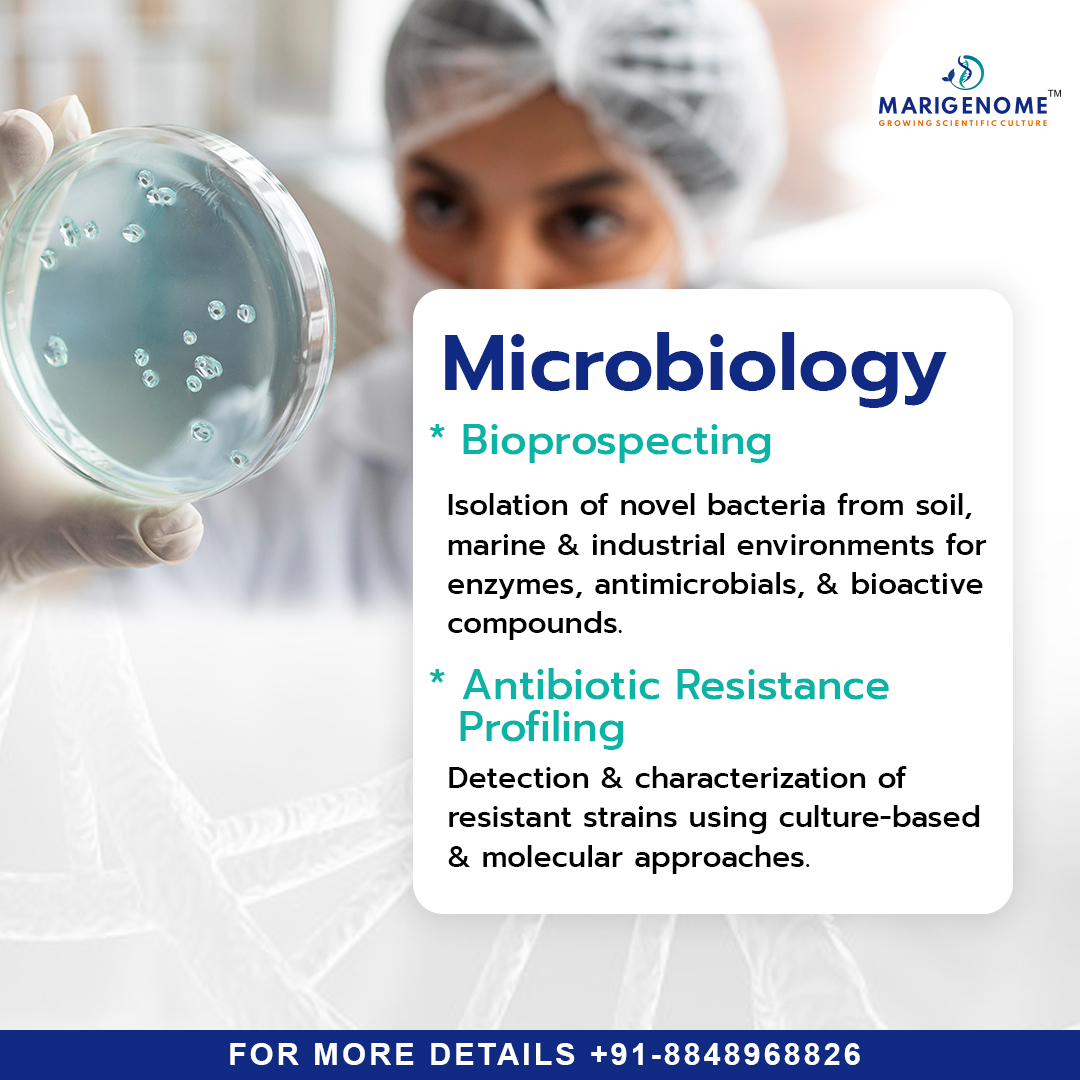

Basic Microbiology Techniques
Dates: August 25th to 30th, 2025
Fee: ₹5,000 + 18% GST
Eligibility: UG/PG Students, Research Scholars, Early Career
Professionals
Overview
This intensive workshop provides hands-on training in essential
microbiological techniques...